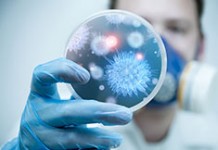

Архив
Инфекции могут сделать вас глупым! Как не заболеть?
Эксперты считают, что патологическая активность ряда распространенных микробов может приводить к проблемам с памятью. Ученые из университета Майами (штат Флорида, США) и Колумбийского университета (штат...
Бактерии управляют вашим настроением
Последние исследования однозначно свидетельствуют в пользу того, что мозг и пищеварительный тракт неразрывно связаны: диета и кишечные бактерии способны влиять на наше поведение, мысли...
Воспаленное ухо? Что лучше: таблетки или растворы?
С наружным отитом сталкивался каждый из нас. Поплавали в холодной речке или прошлись без шапки под пронизывающим ветром – и вот вы уже счастливый...
Мифы о личной гигиене. Нужно ли так часто мыться?
Такие привычки как мытье рук и чистка зубов прочно вошли в нашу жизнь, и мы редко задумываемся над тем, насколько они нам нужны. Наша...
Зубная щетка полна бактериями из попы! Как не заболеть!
Ученые обнаружили, что на одной зубной щетке может находиться до ста миллионов бактерий, в том числе и таких, как кишечные палочки, вызывающие расстройства пищеварения,...
Самые странные способы не заболеть
Если бы у вас спросили: «Как не заболеть?», то, скорее всего, вы бы ответили, что следует принимать антиоксиданты и витамин С. Оказывается, есть некоторые...
Прыщи можно вылечить без антибиотиков
Особые вирусы могут стать мощным терапевтическим средством в борьбе против прыщей, считают ученые. Микробом, который играет ключевую роль в развитии этого пренеприятнейшего заболевания кожи, является...
Альтернатива антибиотикам?
Несмотря на то, что антибиотики остаются главным средством против бактериальных инфекций в арсенале лечащего врача, ученые упорно ищут новый способ бороться с микробами. Новый тренд...